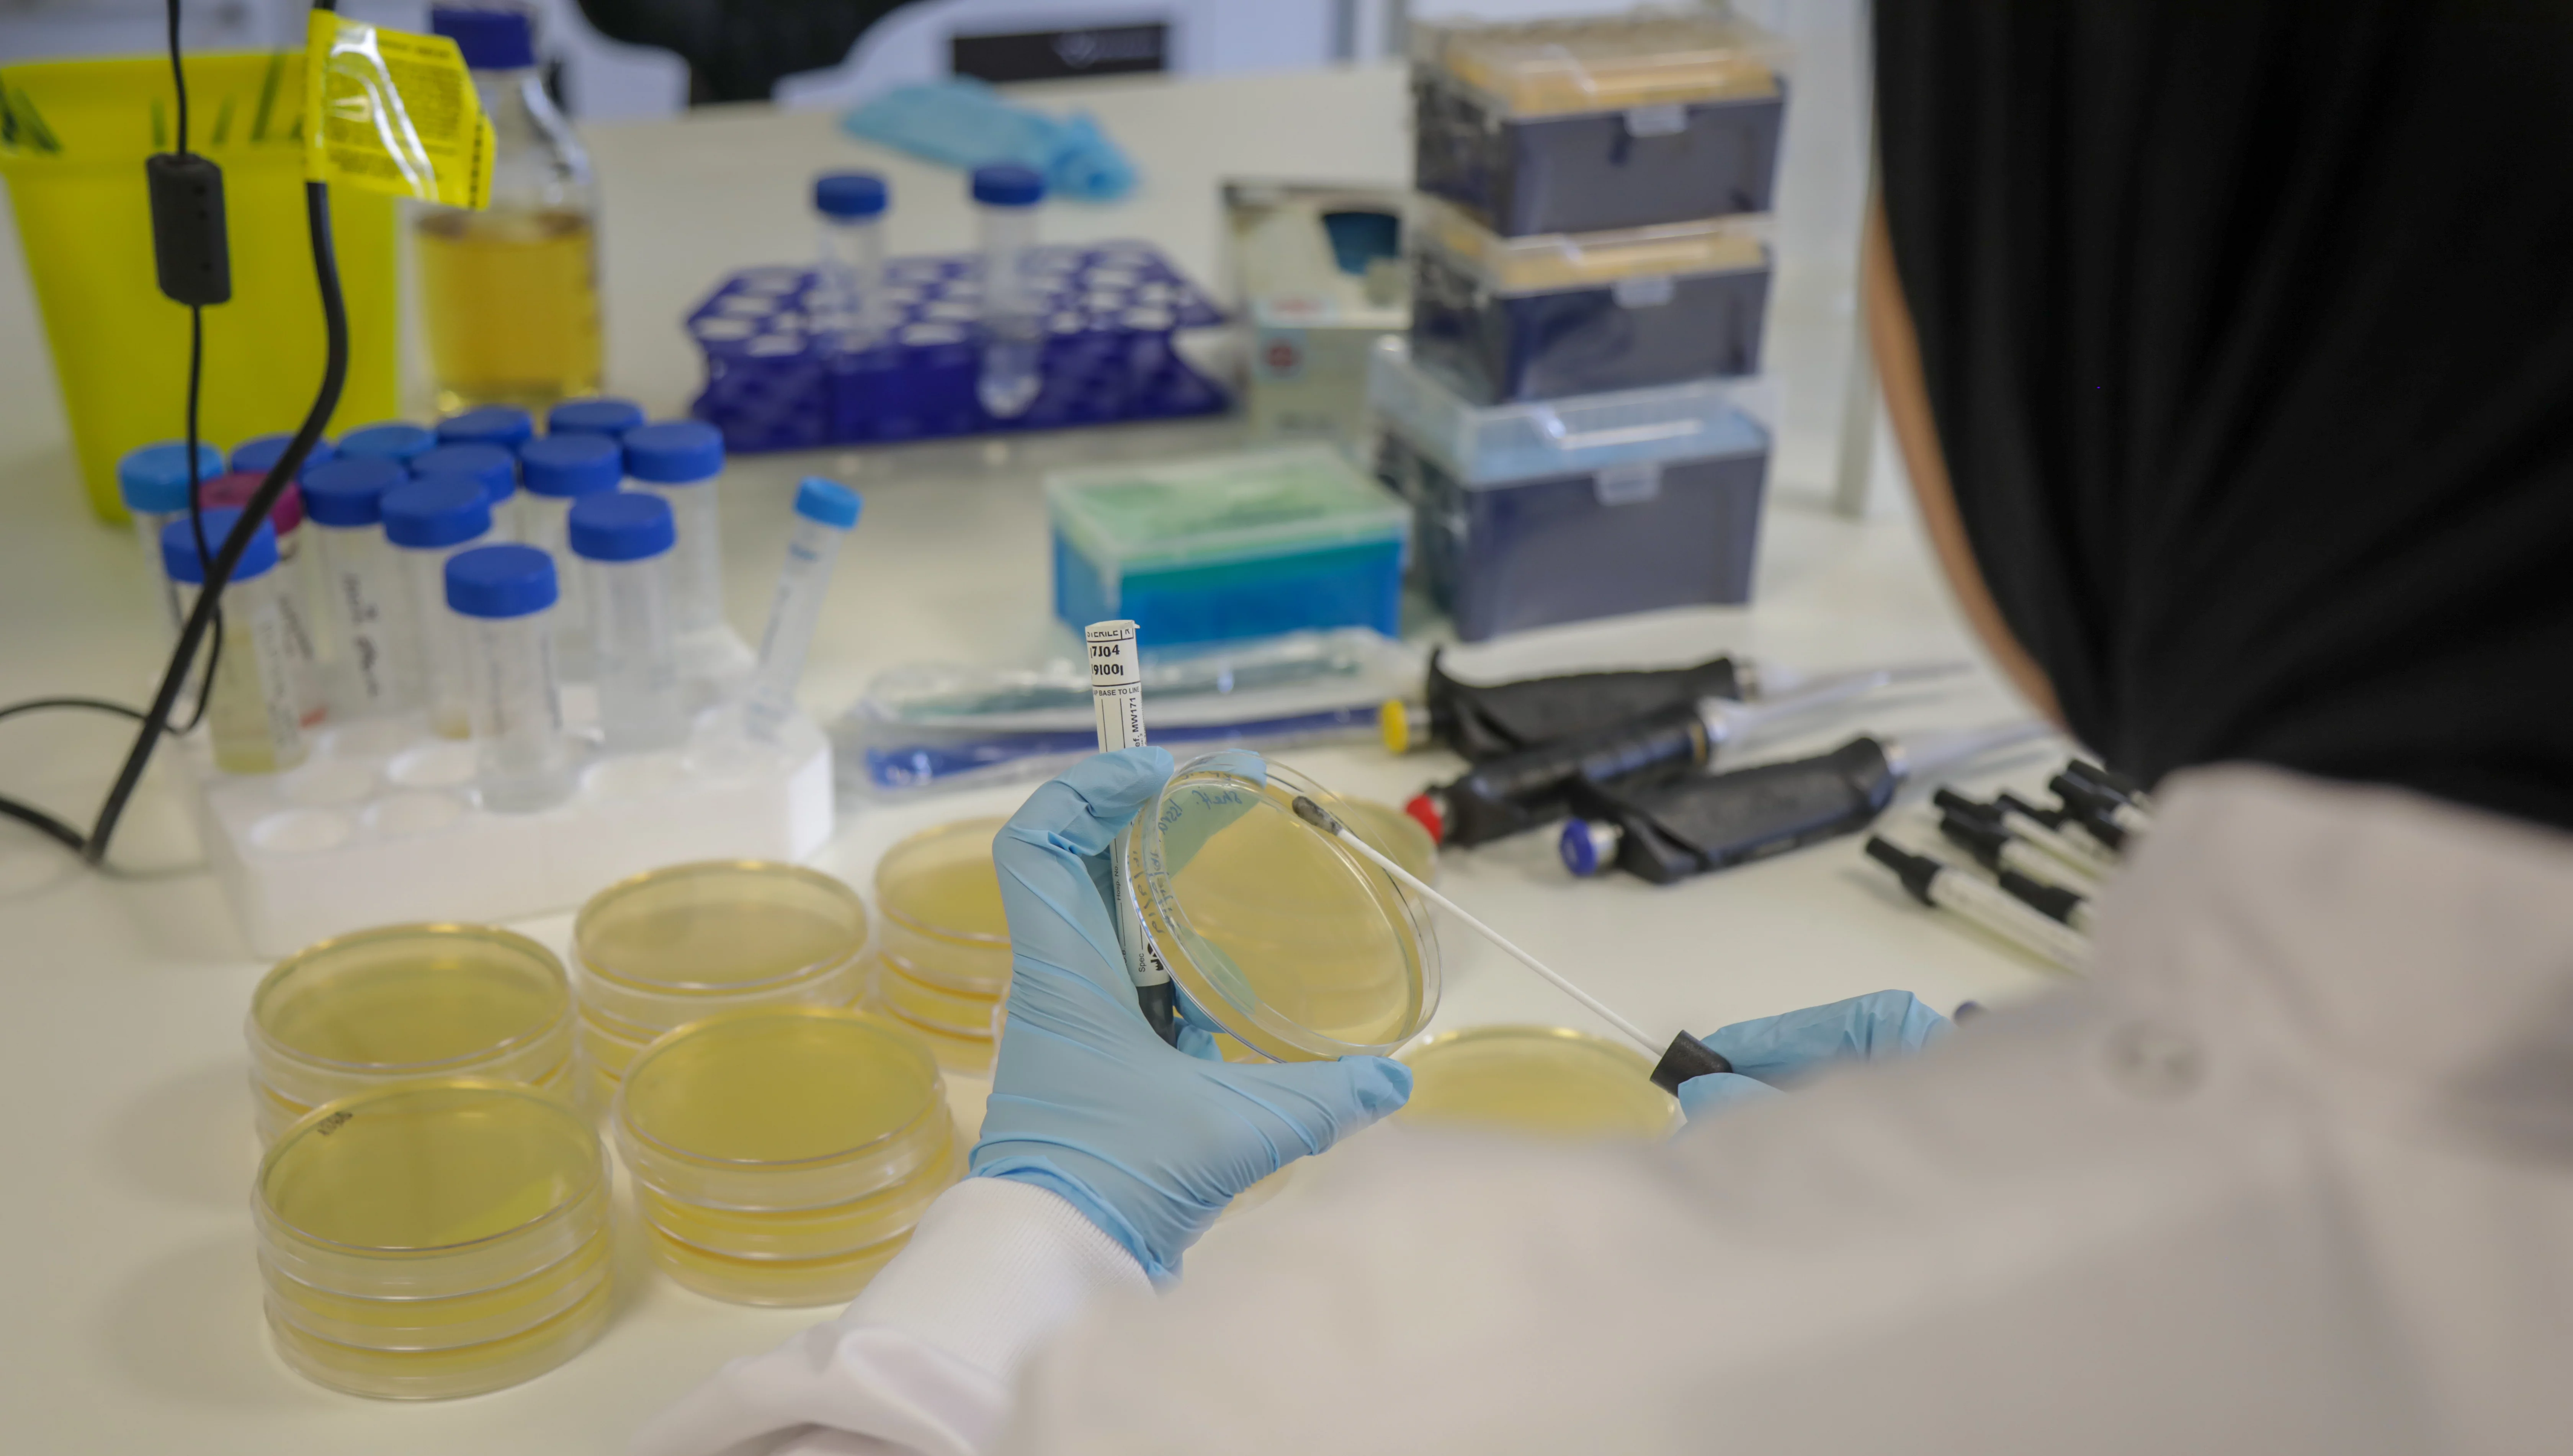
Gardp Liverpool Mou 2023

HERA, WHO and GARDP join forces to counter the growing threat of antimicrobial resistance

Geneva, 19 May 2023 – Representatives from the European Commission’s Health Emergency Preparedness and Response Authority (HERA), WHO and GARDP met in Geneva on 11 May, … HERA, WHO and GARDP join forces to counter the growing threat of antimicrobial resistance